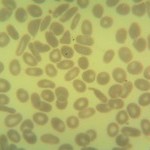
Foto da extensão sanguínea 2
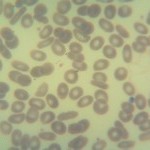
Foto da extensão sanguínea 3
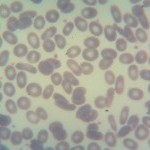
Foto da extensão sanguínea 4

Caso nº 12
Caso Clínico #14
Local: Curitiba-PR
Mês / Ano: Outubro/2014
Assuntos relacionados: ELIPTOCITOSE CONGÊNITA. SEXO FEMININO.
Quadro Clínico
Paciente do sexo feminino, 14 anos.
Com base nos dados clínicos e laboratoriais, propomos as seguintes questões para discussão do caso:
Com base no resultado do hemograma e nas fotos da extensão sanguínea indique a hipótese diagnóstica laboratorial e faça uma breve discussão sobre sua escolha.
Referências Bibliográficas
SILVA, Paulo Henrique, et al. Hematologia Laboratorial: teoria e procedimentos. Porto Alegre, Ed. Artmed, 2016.
Dados Laboratoriais
-
Eritrócitos
4.740.000
Hemoglobina
14,0
Volume globular
43,0
VCM
90,7
HCM
29,5
CHCM
32,5
Leucócitos
5.300
Plaquetas
210.000
Eosinófilos
09
Basófilos
01
Linfócitos
51
Monócitos
03
Bastonetes
02
Segmentados
34
Neutrófilos
36
Eliptócitos +++
Respostas da discussão
Hipótese diagnóstica laboratorial
Eliptocitose congênita (hereditária) comum.
Discussão do caso laboratorial
A eliptocitose é uma doença de caráter autossômico dominante e sua frequência tende a ser maior do que a esferocitose hereditária. Estudos epidemiológicos indicam que na região norte da Europa a incidência da eliptocitose é duas vezes maior que a esferocitose hereditária. Em mais de 30% da população aborígena do sudeste asiático a eliptocitose hereditária está presente. No geral, um caso de eliptocitose hereditária ocorre a cada 5.000 nascimentos. A eliptocitose hereditária pode ser classificada de maneira geral em quatro grandes grupos: (1) eliptocitose hereditária comum, (2) piropoiquilocitose,(3) eliptocitose esferocítica e (4) eliptocitose estomatocítica. O quadro 1 mostra a classificação da eliptocitose.
1 - ELIPTOCITOSE CONGÊNITA (HEREDITÁRIA) COMUM: é a forma mais frequente de eliptocitose hereditária em nosso meio e tem expressividade clinica que varia de totalmente assintomática a casos de hemólise intensa. Episódios de hemólise esporádica são observados em alguns indivíduos durante infecções, na gravidez, no puerpério ou quando a microcirculação fica comprometida, por exemplo, por esplenomegalia, coagulação intravascular disseminada ou na púrpura trombocitopênica trombótica. A patologia é muitas vezes descoberta pela visualização de muitos eliptócitos na extensão sanguínea (variando entre 15 a 100%). A concentração de hemoglobina e as constantes corpusculares (VCM, HCM e CHCM) são normais. A contagem de reticulócitos geralmente não está aumentada e nos casos de crises hemolíticas o RDW pode elevar-se. Como a severidade da eliptocitose varia consideravelmente, sinais de hemólise podem ser evidenciados, como policromatofilia e elevação na contagem de reticulócitos. Em torno de 5 a 20% dos casos ocorre uma anemia hemolítica que varia de moderada a intensa com hemoglobina variando de 9 a 12 g/dl e contagem de reticulócitos entre 20 a 25%.
2 - PIROPOIQUILOCITOSE HEREDITÁRIA: é uma doença de herança autossômica recessiva, rara, que se caracteriza por anemia hemolítica intensa com presença de microesferócitos, microeliptócitos e piropoiquilócitos. Em função dos piropoiquilócitos, o VCM pode ser extremamente baixo (entre 30 a 50 fentolitros), a hemoglobina fica entre 5 a 9,0 g/dl, a contagem de reticulócitos entre 13 a 35% e o RDW apresenta elevação. O nome desta doença vem do fato das hemácias normais suportarem uma temperatura até 49º C. Na piropoiquilocitose os eritrócitos fragmentam-se em temperaturas entre 45 a 46º C. A fragilidade osmótica está aumentada.
3 - ELIPTOCITOSE ESFEROCÍTICA: este termo é utilizado para descrever uma variante da eliptocitose que é caracterizada morfologicamente por células que são mais arredondadas do que microesferócitos e microeliptócitos. São observados na extensão sanguínea tanto eliptócitos quanto esferócitos. Os indivíduos afetados apresentam um processo hemoltico não compensado e apresentam predisposição para crises aplásicas. Como na esferocitose hereditária, a fragilidade osmótica é aumentada. Estudos em algumas famílias portadores da doença, apontou para a deficiência da proteína 4. Como tratamento indica-se a esplenectomia, que na maioria dos casos é curativa.
4 - ELIPTOCITOSE ESTOMATOCÍTICA: Também denominada ovalocitose hereditária é um distúrbio distinto e homogeneo que ocorre na Nova Guiné, nas ilhas Salomão, em populações da Indonésia e das Filipinas. A herança é autossômica dominante. O defeito genético é a deleção no gene da banda 3, que causa a ligação desta proteína com a anquirina, reduzindo sua mobilidade e rigidez. Na maioria dos casos não há anemia. Os eritrócitos são redondos ou ovais e é comum a presença de estomatócitos na extensão sanguínea.
As proteínas de membrana envolvidas nestas patologias são espectrina, proteína 4.1 e glicoforina C. A espectrina participa tanto das interações verticais como das horizontais, a proteína 4.1 participa das interações horizontais e a glicoforina C das verticais. As alterações mais comuns estão relacionadas com mutações no gene da espectrina, seguida de mutações na proteína 4.1 e por fim as da glicoforina C. O eliptócito forma-se na corrente circulatória, não sendo liberado nesta forma da medula óssea e provavelmente adquire esta forma após passar pelos sinusóides do baço ou pela microcirculação.